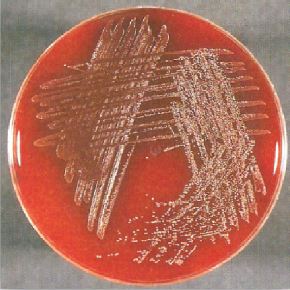

النبات

مواضيع عامة في علم النبات

الجذور - السيقان - الأوراق

النباتات الوعائية واللاوعائية

البذور (مغطاة البذور - عاريات البذور)

الطحالب

النباتات الطبية


الحيوان

مواضيع عامة في علم الحيوان

علم التشريح

التنوع الإحيائي

البايلوجيا الخلوية


الأحياء المجهرية

البكتيريا

الفطريات

الطفيليات

الفايروسات


علم الأمراض

الاورام

الامراض الوراثية

الامراض المناعية

الامراض المدارية

اضطرابات الدورة الدموية

مواضيع عامة في علم الامراض

الحشرات


التقانة الإحيائية

مواضيع عامة في التقانة الإحيائية


التقنية الحيوية المكروبية

التقنية الحيوية والميكروبات

الفعاليات الحيوية

وراثة الاحياء المجهرية

تصنيف الاحياء المجهرية

الاحياء المجهرية في الطبيعة

أيض الاجهاد

التقنية الحيوية والبيئة

التقنية الحيوية والطب

التقنية الحيوية والزراعة

التقنية الحيوية والصناعة

التقنية الحيوية والطاقة

البحار والطحالب الصغيرة

عزل البروتين

هندسة الجينات


التقنية الحياتية النانوية

مفاهيم التقنية الحيوية النانوية

التراكيب النانوية والمجاهر المستخدمة في رؤيتها

تصنيع وتخليق المواد النانوية

تطبيقات التقنية النانوية والحيوية النانوية

الرقائق والمتحسسات الحيوية

المصفوفات المجهرية وحاسوب الدنا

اللقاحات

البيئة والتلوث


علم الأجنة

اعضاء التكاثر وتشكل الاعراس

الاخصاب

التشطر

العصيبة وتشكل الجسيدات

تشكل اللواحق الجنينية

تكون المعيدة وظهور الطبقات الجنينية

مقدمة لعلم الاجنة


الأحياء الجزيئي

مواضيع عامة في الاحياء الجزيئي


علم وظائف الأعضاء


الغدد

مواضيع عامة في الغدد

الغدد الصم و هرموناتها

الجسم تحت السريري

الغدة النخامية

الغدة الكظرية

الغدة التناسلية

الغدة الدرقية والجار الدرقية

الغدة البنكرياسية

الغدة الصنوبرية

مواضيع عامة في علم وظائف الاعضاء

الخلية الحيوانية

الجهاز العصبي

أعضاء الحس

الجهاز العضلي

السوائل الجسمية

الجهاز الدوري والليمف

الجهاز التنفسي

الجهاز الهضمي

الجهاز البولي


المضادات الميكروبية

مواضيع عامة في المضادات الميكروبية

مضادات البكتيريا

مضادات الفطريات

مضادات الطفيليات

مضادات الفايروسات

علم الخلية

الوراثة

الأحياء العامة

المناعة

التحليلات المرضية

الكيمياء الحيوية

مواضيع متنوعة أخرى

الانزيمات
الحالات المرضية البكتيرية : الحالة الثامنة والثلاثون
المؤلف:
عبد الرزاق سليمان التومي ، محمد محمد الامام ، عبد الباسط رمضان
المصدر:
اساسيات التشخيص البكتريولوجي المعملي والسريري
الجزء والصفحة:
6-9-2016
2239
الحالات المرضية البكتيرية : الحالة الثامنة والثلاثون
مريض يعاني من فقدان الوزن وتوعك عام وحمى منذ عدة أسابيع ، عند فحص المريض وجد أنه يعاني من لغط القلب cardiac murmur وتضخم الطحال splenomegaly كما لوحظ وجود splinter haemorrages وأثناء فحص عينة البول مجهرياً لوحظ وجود دم كما اظهرت المزرعة البكتيرية لعينة البول نمواً لمستعمرات بكتيرية كما في الشكل رقم 1 والشكل رقم 2 .
الشكل 1 : المزرعة البكتيرية

الشكل رقم 2 التشخيص المجهري
الأسئلة :
1- ما تشخيصك السريري المتوقع للمرض ؟ وما هو الكائن الممرض ؟
2- كيف تتم معالجة هذا المريض؟
3- ما هي الكائنات الممرضة التي قد تحدث مثل هذه الإصابة؟
الإجابات :
1- هذا المريض يعاني من التهاب بطانة القلب endocarditis نتيجة الإصابة البكتيرية وهي تظهر فجأة كما في حالة هذا المريض وقد تظهر على هيئة حادة وذلك على هيئة قصور في وظائف القلب cardiac failure نتيجة تمزق الصمام أو بأعراض تخص الجهاز العصبي المركزي نتيجة مضاعفات ناتجة عن الإنسداد.
تحدث الإصابة عند التصاق وتكاثر الخلايا البكتيرية بوريقات الصمام valve leaflets مما يؤدي إلى تضرر بطانة القلب نتيجة التدفق الهائل للدم ، على سبيل المثال الصمام ذو الشرفتين bicuspid valve أو نتيجة لوجود سبب أدى إلى الاضرار بصمام القلب مثل مرض الحمى الروماتيزمية وقد يحدث أن تستعمر بعض الأنواع البكتيرية منطقة صمام القلب مما يؤدي إلى إلتهاب بطانة القلب حيث تتكاثر في الصمام متجنبة الجهاز المناعي للشخص المصاب وذلك بإحاطة نفسها بطبقة ليفين وتكدس الصفيحات fibrin & platelet مكونة نابتات مرئية macroscopic vegetations vegetations وقد تغزو البكتيريا الاوعية الدموية مما يؤدي إلى انكفاء الدم وقصور في وظائف القلب وقد تحدث مضاعفات جهازية إما نتيجة للتفاعلات المناعية مثل التهاب الكلية وذلك نتيجة تكون مركب مناعي immunocomplex deposition في الكلية ، أو حدوث بعض الإنسدادات مثل ما قد يحدث في الجهاز العصبي المركزي مما يؤدي لظهور أعراض عصبية بؤرية focal neurogical and symptoms.
ومن المسببات الرئيسية لإلتهاب بطانة القلب نجد viridans streptococci كما في حالة هذا المريض وهذا الجنس البكتيري عبارة عن كرويات موجبة لصبغة جرام مرتبة في سلاسل وتنتج محلل للدم من نوع ألفا عند زراعتها على الوسط الغذائي blood agar . ويتكون هذا الجنس من عدة انواع مختلفة منها النوع البكتيري S. sanguis وهو من أكثر المسببات لإلتهاب بطانة القلب ويتواجد في البلعوم الفموي مكوناً جزءاً من الفلورا الطبيعية.
2- إذا كان الجنس البكتيري Streptococcus Spp المعزول حساس للمضاد الحيوي penicillin ( بتركيز مثبط أقل من 1.0 جم/لتر) فيتم علاج هذا المريض لمدة أسبوعين بحقن المضاد الحيوي Benzylpenicillin مع المضاد الحيوي gentamicin عن طريق الوريد يتبع ذلك تناول المضاد الحيوي ampicillin فموياً مع المضاد الحيوي probenecid أيضاً لمدة أسبوعين . أما إذا كان أقل حساسية للمضاد الحيوي penicillin (بتركيز مثبط اكثر من 1 جم/لتر) عندها يتم إعطاء المضاد الحيوي Benzylpenicillin مع gentamicin لمدة أربعة أسابيع يتبعها المضاد الحيوي ampicillin والمضاد الحيوي probenecid لمدة أسبوعين ويعتمد ذلك على حساسية الكائن الممرض المعزول للمضاد الحيوي وهناك مضادات حيوية أخرى قد تستعمل مثل مزيج من B-Lactam مع aminoglycoside أو glucopeptide مع أو بدون aminoglycoside .
ويعرف التركيز المثبط MIC على انها أقل كمية من المضاد الحيي كافية للقضاء على الكائن الدقيق الممرض وهو اختبار معملي يتم باستعمال تخفيفات مضاعفة من المضاد الحيوي باستعمال انابيب اختبار تحتوي على حساء broth يوضع به تركيز محدد من الجنس البكتيري Streptococcus Spp وبعد وضعه في الحاضنة يتم ملاحظة وجود العكارة في الأنابيب مما يدل على وجود نمو بكتيري ويبدأ الاختبار من اعلى تركيز للمضاد الحيوي وهو ما يعرف بالتركيز المثبط.
3- هناك بعض الكائنات تم عزلها عدة مرات ومن أكثر هذه الكائنات عزلاً نجد الجنس البكتيري viridans streptococci التي تحتوي على النوع البكتيري S. bovis والنوع البكتيري Enterococcus faecalis اللذان يتواجدان بالقناة المعد ــ معوية أكثر من تواجدهم في البلعوم الفموي ويعتبر نوع البكتيري S. aureus المسبب الرئيسي لإلتهاب بطانة القلب في المرضى المدمنين على استعمال الأدوية وتصيب بالتحديد صمامات القلب اليمنى.
ويعتبر الجنس البكتيري Staphylococcus Spp السالب لاختبار التجلط (coagulase - ve) من المسببات لإلتهاب بطانة القلب في الأشخاص المزودين بصمامات القلب الصناعية.
الاكثر قراءة في البكتيريا
اخر الاخبار
اخبار العتبة العباسية المقدسة
الآخبار الصحية

قسم الشؤون الفكرية يصدر كتاباً يوثق تاريخ السدانة في العتبة العباسية المقدسة
"المهمة".. إصدار قصصي يوثّق القصص الفائزة في مسابقة فتوى الدفاع المقدسة للقصة القصيرة
(نوافذ).. إصدار أدبي يوثق القصص الفائزة في مسابقة الإمام العسكري (عليه السلام)